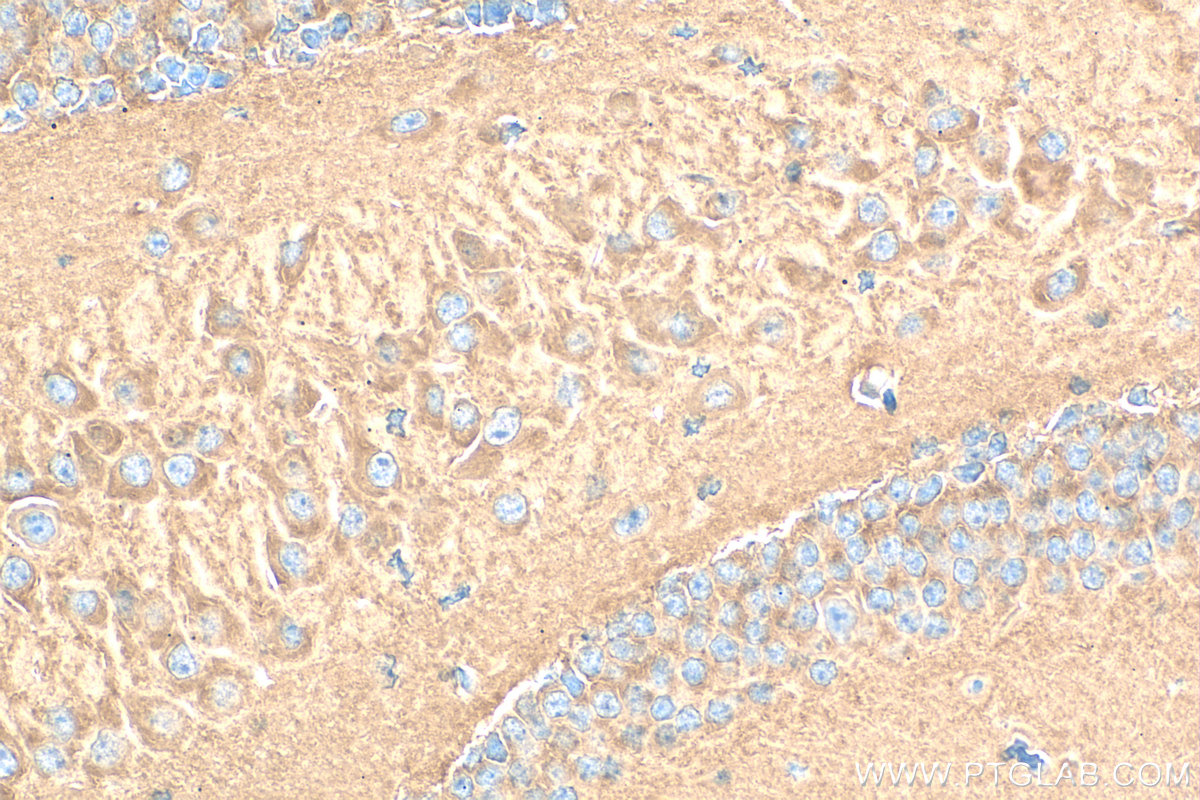
Immunohistochemistry (IHC) staining of mouse brain tissue using AP2B1 Polyclonal antibody (15690-1-AP)

Tested Applications
| Positive WB detected in | HeLa cells, SH-SY5Y cells, K-562 cells, C6 cells, NIH/3T3 cells |
| Positive IP detected in | K-562 cells |
| Positive IHC detected in | mouse brain tissue Note: suggested antigen retrieval with TE buffer pH 9.0; (*) Alternatively, antigen retrieval may be performed with citrate buffer pH 6.0 |
| Positive IF/ICC detected in | HeLa cells |
Recommended dilution
| Application | Dilution |
|---|---|
| Western Blot (WB) | WB : 1:5000-1:50000 |
| Immunoprecipitation (IP) | IP : 0.5-4.0 ug for 1.0-3.0 mg of total protein lysate |
| Immunohistochemistry (IHC) | IHC : 1:50-1:500 |
| Immunofluorescence (IF)/ICC | IF/ICC : 1:1000-1:4000 |
| It is recommended that this reagent should be titrated in each testing system to obtain optimal results. | |
| Sample-dependent, Check data in validation data gallery. | |
Published Applications
| KD/KO | See 1 publications below |
| WB | See 13 publications below |
| IF | See 4 publications below |
Product Information
15690-1-AP targets AP2B1 in WB, IHC, IF/ICC, IP, ELISA applications and shows reactivity with human, mouse, rat samples.
| Tested Reactivity | human, mouse, rat |
| Cited Reactivity | human, mouse, pig, monkey |
| Host / Isotype | Rabbit / IgG |
| Class | Polyclonal |
| Type | Antibody |
| Immunogen |
CatNo: Ag8248 Product name: Recombinant human AP2B1 protein Source: e coli.-derived, PGEX-4T Tag: GST Domain: 598-951 aa of BC006201 Sequence: GSTDAGDSPVGTTTATNLEQPQVIPSQGDLLGDLLNLDLGPPVNVPQVSSMQMGAVDLLGGGLDSLLGSDLGGGIGGSPAVGQSFIPSSVPATFAPSPTPAVVSSGLNDLFELSTGIGMAPGGYVAPKAVWLPAVKAKGLEISGTFTHRQGHIYMEMNFTNKALQHMTDFAIQFNKNSFGVIPSTPLAIHTPLMPNQSIDVSLPLNTLGPVMKMEPLNNLQVAVKNNIDVFYFSCLIPLNVLFVEDGKMERQVFLATWKDIPNENELQFQIKECHLNADTVSSKLQNNNVYTIAKRNVEGQDMLYQSLKLTNGIWILAELRIQPGNPNYTLSLKCRAPEVSQYIYQVYDSILKN Predict reactive species |
| Full Name | adaptor-related protein complex 2, beta 1 subunit |
| Calculated Molecular Weight | 105 kDa |
| Observed Molecular Weight | 100-105 kDa |
| GenBank Accession Number | BC006201 |
| Gene Symbol | AP2B1 |
| Gene ID (NCBI) | 163 |
| RRID | AB_2056351 |
| Conjugate | Unconjugated |
| Form | Liquid |
| Purification Method | Antigen affinity purification |
| UNIPROT ID | P63010 |
| Storage Buffer | PBS with 0.02% sodium azide and 50% glycerol, pH 7.3. |
| Storage Conditions | Store at -20°C. Stable for one year after shipment. Aliquoting is unnecessary for -20oC storage. 20ul sizes contain 0.1% BSA. |
Background Information
AP2B1 is a component of the adaptor protein complex 2 (AP-2). AP complexes are cytosolic heterotetramers that mediate the sorting of membrane proteins in the secretory and endocytic pathways. AP complexes are involved in the formation of clathrin-coated vesicles (CCVs) by recruiting the scaffold protein, clathrin. AP complexes also play a pivotal role in the cargo selection by recognizing the sorting signals within the cytoplasmic tail of integral membrane proteins. AP-2 works on the plasma membrane to internalize cargo in clathrin-mediated endocytosis.
Protocols
| Product Specific Protocols | |
|---|---|
| IF protocol for AP2B1 antibody 15690-1-AP | Download protocol |
| IHC protocol for AP2B1 antibody 15690-1-AP | Download protocol |
| IP protocol for AP2B1 antibody 15690-1-AP | Download protocol |
| WB protocol for AP2B1 antibody 15690-1-AP | Download protocol |
| Standard Protocols | |
|---|---|
| Click here to view our Standard Protocols |
Publications
| Species | Application | Title |
|---|---|---|
Emerg Microbes Infect CD1d facilitates African swine fever virus entry into the host cells via clathrin-mediated endocytosis | ||
Elife Syncytin-mediated open-ended membrane tubular connections facilitate the intercellular transfer of cargos including Cas9 protein | ||
PLoS Pathog Pseudorabies virus inhibits progesterone-induced inactivation of TRPML1 to facilitate viral entry | ||
Sci China Life Sci NPC1-regulated dynamic of clathrin-coated pits is essential for viral entry. | ||
J Virol The G protein-coupled receptor FFAR2 promotes internalization during influenza A virus entry.
| ||
Viruses Pseudorabies Virus Inhibits Expression of Liver X Receptors to Assist Viral Infection. |